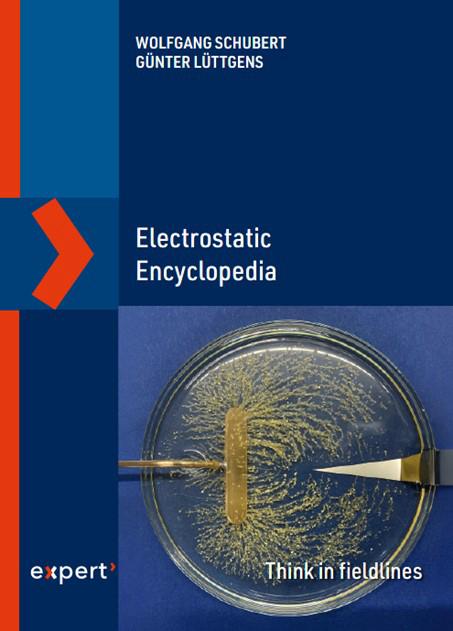

SCHUBERT-GMD, SACHVERSTÄNDIGER-GUTACHTEN-INDUSTRIEBERATUNG-ELEKTROSTATIK-DRUCKVERFAHREN
19.11. - 20.11.2024 TAE - Technische Akademie Esslingen e.V.
Referent Wolfgang Schubert.
🔗Zündgefahren in explosionsgefährdeten Bereichen 19.11.2024, TAE
Gefahren infolge elektrostatischer Aufladungen
🔗Elektrostatik Aufbauseminar, 20.11.2024, TAE
Expertenworkshop mit praktischen Messübungen
8. Februar 2024 Verein Deutscher Druckingenieure e.V.
VDD-webinar "Beseitigung elektrostatischer Aufladungen auf Materialbahnen in Produktionsmaschinen"
Referent: Wolfgang Schubert
20. März 2024 Webinar: EFCE Spotlight talks, Working Party on Static Electricity in Industry
Charging of Material Web in the Process Industry (W. Schubert, Germany)
Lightning Protection of Chemical Industry (Prof. I. Kiss, Hungary)
Conclusion (Prof. P. Llovera, Spain)
18. April 2024 iP³ Institute for Printing, Processing and Packaging Leipzig, HTWK Leipzig
und Fachverband der Druckindustrie und Informationsverarbeitung e.V. Bezirk Berlin
laden zur Fachveranstaltung "Elektrostatik" ein.
Referent Wolfgang Schubert.
Seminare an der TAE - Technische Akademie Esslingen e.V.
22.11.2023, Elektrostatik Aufbauseminar, Expertenworkshop mit praktischen Messübungen
21.11.2023 Zündgefahren in explosionsgefährdeten Bereichen, Gefahren infolge elektrostatischer Aufladungen
4.5./5.5.2023 Elektrisch leitende Kunststoffe, Selbstleitende Polymere, Compounds mit leitenden Additiven, Elektromobilität, Elektrostatik/Antistatik, Elektromagnetische Abschirmung
29.11.2022 Elektrostatik Aufbauseminar, Expertenworkshop mit praktischen Messübungen
13.10.2022 Zündgefahren in explosionsgefährdeten Bereichen
2.7./3.7.2020 Elektrisch leitende Kunststoffe
4.12.2019 Elektrostatik Aufbauseminar, Expertenworkshop mit praktischen Messübungen
9.5./10.5.2019 Elektrisch leitende Kunststoffe
Innoform®Tagung
🔗www.innoform-coaching.de9. Expertentreff Verpackungsdruck 29./30. November 2023, Osnabrück
5.3.2020
Gasexperten Seminare
2020 Wiesengrundakademie in Bad HindelangGasfachtagung für Industrie und Handwerk
» Electrostatic Encyclopedia
Herausgeber: expert verlag ein Imprint von Narr Francke Attempto Verlag
Erscheinungstermin: 13. Oktober 2025
Auflage 1.
Sprache Englisch
Seitenzahl der Print-Ausgabe, 450 Seiten
ISBN-10 3381117017
ISBN-13 978-3381117017
» Static Electricity

Übersetzung ins chinesische:
🔗Static Electricity, Understanding, Controlling, Applying ISBN 979-7-118-12782-9
» Praxislexikon Statische Elektrizität
Rezension Bühnentechnische Rundschau BTR 04|2023
Dieses hochwertige Lexikon erklärt rund 2100 Begriffe mit 330 Abbildungen und rund 5300 Querverweisen aus dem Bereich der Statischen Elektrizität. Diese Querverbindungen zu Sachverhalten, Normen und 270 Literaturangaben ermöglichen es, sich ein Grundverständnis zu elektrostatischen Erscheinungen anzueignen.
Im Lexikon sind die Beurteilungskriterien und die messtechnischen Möglichkeiten, Verfahren, Geräte und Systeme und deren Nutzanwendung zusammengestellt. Es befasst sich außerdem mit den elektrostatischen Aufladungen als Ursache von Bränden und Explosionen aus vielen Bereichen der Industrie bis hin zu den Erscheinungen in der Umwelt. Zu finden sind auch die wichtigsten mathematischen Formeln, 170 Daten brennbarer Gase und Dämpfe mit den Angaben der CAS-Nummer bis hin zu deren UEG/OEG, Zündtemperatur und Leitfähigkeiten sowie die Daten zu rund 50 gängigen Kunststoffen. Eine Tabelle mit den Permittivitäten häufig genutzter Stoffe rundet das sehr verständlich, geradezu freundlich geschriebene Lexikon ab.


(DOI: 10.24053/9783816985068)
» Electrostatic charging of material webs in gravure printing presses
🔗 (journal-of-electrostatics 2024)sciencedirect.com
🔗 download (Material web in Gravure machine Goetz.pdf) pdf 6,1MB
🔗 link (Material web in Gravure machine)

» Can Velcro be used in potentially hazardous areas?
🔗 download (VelcroohsawaIEJ24.pdf) pdf 48KB

» Electrostatic charging of material webs in production machines and how to
eliminate it
🔗 (journal-of-electrostatics 2024)sciencedirect.com
🔗 download (Electrostatic on material web and elimination-opt.pdf) pdf 913KB
🔗 link (Electrostatic on material web and elimination)

» Beseitigung elektrostatischer Aufladungen auf Materialbahnen in Produktionsmaschinen
🔗 download (VVD W-Schubert Materialbahn-k.pdf) pdf 702KB
» Electrostatic charging phenomena on material web electro field meter measurements and their interpretation
(DOI: 10.1016/j.elstat.2022.103681)
» Fachbuch „Statische Elektrizität
Flyer 🔗download pdf 472KB
1. Auflage November 2019, 472 Seiten, Hardcover, 296 Bilder (198 Farbabbildungen)
109,00 EUR, ISBN 978-3-527-41372-0, Wiley-VCH , Berlin
🔗Fachbuch Statische Elektrizität
» Aufladungsphänomene an Materialbahnen
(erster Teil erschienen in Flexo+Tiefdruck, Heft 5/2019)
» ESD Forum
Auszug aus dem Tagungsband 16. ESD-Forum 2019, Ladungszerfall-Messung
» Gefahr erkannt, Gefahr gebannt
Der richtige Umgang mit elektrostatischen Aufladungen im Alltag
Dipl.-Ing. Wolfgang Schubert
Zeitschrift: 🔗Beitrag FLEXO+Tief-Druck I 2018 S.10 bis S.13 pdf 2,5MB
» Fachbuch „Static Electricity

Flyer 🔗download pdf 470KB
Das Buch können Sie im Wiley-Verlag bestellen:
🔗www.wiley-vch.de ISBN: 978-3-527-34128-3.
Siehe auch:
ELSTATIK Stiftung, Günter & Sylvia Lüttgens, Elektrostatik / Explosionsschutz
BG RCI Berufsgenossenschaft Rohstoffe und chemische Industrie
🔗www.bgrci.de/exinfode/ex-schutz-wissen/wichtige-medien/fachbuecher/
» Elektrostatik und Gefahrgut
Entstehung - Gefahren- Gegenmaßnahmen
Dr. Monika Kaßmann / Wolfgang Schubert
Zeitschrift: 🔗Beitrag GEFAHRGUT PROFI 5/2017 S.24 bis S.27 pdf 2,5MB
» Optimierung durch Oberflächenbehandlung, Korona- und Plasmavorbehandlung verbessern die Farbhaftung auf Folien
Zeitschrift: 🔗Etiketten-Labels 6-2012 pdf 130KB
» Elektrostatische Ladungen, Das Gefahrenpotential
Zeitschrift: 🔗Bindereport 4/2009 pdf 1MB
» Elektrostatische Ladungen, Nutzanwendungen
Zeitschrift: 🔗Bindereport 3/2009 pdf 505KB
» Elektrostatische Ladungen, Erkennen und Beseitigen
Zeitschrift: 🔗Bindereport 2/2009 pdf 1,2MB
» UV-Technologie, in High-Speed-Variante
Zeitschrift: 🔗Etiketten-Labels 3-2008 pdf 1,2MB
» Ruhende Elektrizität, Grundlagen der Elektrostatik
Zeitschrift: 🔗Etiketten-Labels 2-2008 pdf 375KB
» Oberflächenreinigung von MDF vor der Pulverbeschichtung
Zeitschift: 🔗Holztechnologie 3/08 pdf 670KB
» Lichtdruck, Leipziger Verein bewahrt traditionelle Lichtdruck-Kunst vor dem Aussterben
Zeitschrift: 🔗Fundraiser, Herbst 2006 pdf 390KB
» Lichtdruck-Kunst in digitaler Zeit Referat Leipziger Typotage 2010,
🔗Leipziger Typotage (Rückblick-2010)
» Lichtdruck Mediengeschichte
Wolfgang Schubert, Diplom-Ingenieur für Polygraphie, und Janine Kittler, Lichtdruckerin, über Geschichte und Technik des Lichtdrucks (Video-Beitrag, 2014)
🔗 Deutsches Buch- und Schriftmuseum der Deutschen Nationalbibliothek Leipzig
» Ein Minibuch über den Lichtdruck

verständlich erklärt und gut lesbar geschrieben. Bibliophiler Ledereinband in Handarbeit mit zwei Original Lichtdrucken. (Leipziger Universitätskirche 1968 / Paulinum - Aula und Universitätskirche St. Pauli 2012) 136 Seiten, Format 48 x 60 mm in einem Schuber, der mit einemLichtdruck bezogen ist.
Jeder Schuber ist ein Unikat. Auflage nur 310 Exemplare, nummeriert
ISBN: 978-3-89798-374-8
Preis: 38,00 EUR
» Beitrag zum 11.Bahnlaufseminar, 26.- 27. September 2011, Technische Universität Chemnitz, Institut für Print- und Medientechnik
» Vortrag auf der Tagung VVD 2012 am 22.3.2012, Verarbeitungsmaschinen und Verpackungstechnik
- Praxis trifft Wissenschaft -
© Schubert GMD Industrieberatung
Weidenweg 15, 04425 Taucha
–Fon:+49 34298 67323
–Fax: 03222 6873033
–Mail: ws@schubert-gmd.de
Impressum
Datenschutz

